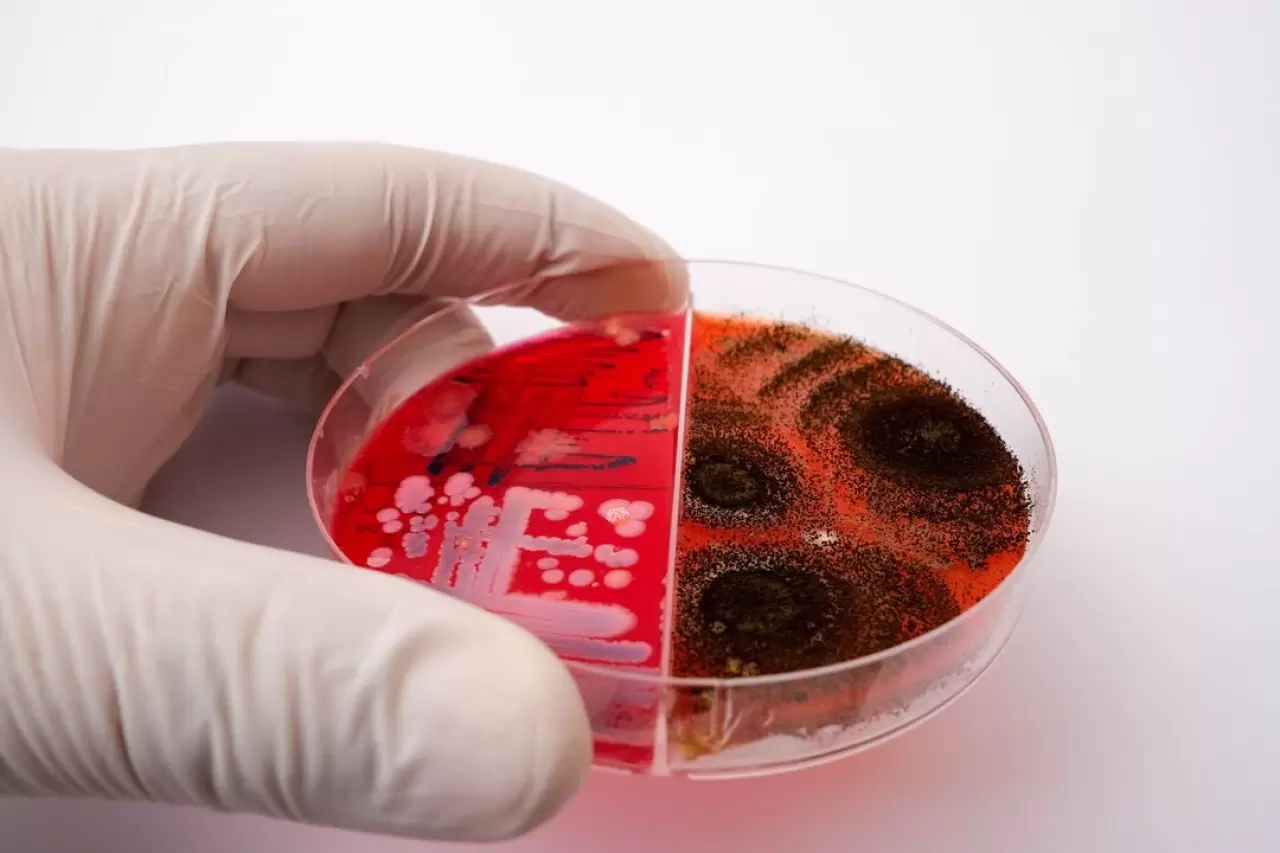

Gözle görülmeyen, kokusuz ve tatsız bir tehdit olan okratoksin, sağlığımızı ciddi şekilde tehlikeye atabiliyor. Bilinçli alışveriş yapmak, uygun saklama koşullarını sağlamak ve ürünleri dikkatle incelemek; bu sinsi düşmana karşı en etkili savunma yöntemleri arasında yer alıyor.
Okratoksin nedir?
Okratoksinler, başlıca Aspergillus ve Penicillium türü küflerin ürettiği, son derece zararlı mikotoksinler. Başta buğday, arpa, kahve çekirdekleri, kuru meyveler, şarap ve baharatlar olmak üzere birçok gıdada, uygun olmayan saklama koşullarında oluşur. Gözle görülmez, tadı ve kokusu fark edilmez; bu yüzden oldukça sinsi bir tehdit olarak değerlendirilir.

Okratoksinin sağlığa zararları nelerdir?
Uzmanlara göre okratoksine uzun süre maruz kalmak, birçok ciddi sağlık sorununa yol açabilir. Ankara Üniversitesi Gıda Güvenliği Anabilim Dalı Öğretim Üyesi Prof. Dr. Ayşe Yıldız, şu uyarıda bulunuyor: "Okratoksin-A, özellikle böbrek dokusuna büyük zarar verir. Uzun vadede böbrek yetmezliği riskini artırabilir. Ayrıca bu toksinin bağışıklık sistemi üzerinde baskılayıcı etkileri vardır. Kanserojen potansiyeli nedeniyle Dünya Sağlık Örgütü tarafından dikkatle izlenmektedir."
Diğer riskler arasında karaciğer hasarı, sinir sistemi üzerinde toksik etkiler ve doğurganlık sorunları da bulunuyor. Özellikle çocuklar ve yaşlılar gibi hassas grupların bu toksine karşı daha savunmasız olduğu vurgulanıyor. 
Okratoksine nasıl maruz kalıyoruz?
Okratoksin maruziyeti genellikle doğrudan tüketilen kontamine (bulaşmış) gıdalarla gerçekleşiyor. İstanbul Üniversitesi Veteriner Fakültesi Mikrobiyoloji Anabilim Dalı’ndan Dr. Mehmet Koç, "Nemli ve sıcak koşullarda saklanan tahıl, kahve veya kuru meyvelerde küf gelişimi başlar. Küflerin gözle görülmese bile toksin üretmesi mümkündür. Yani gıdayı tüketirken küf görmesek bile okratoksine maruz kalabiliriz” diyor.
Okratoksinden nasıl korunabiliriz?
Okratoksin tehlikesinden korunmak için alınabilecek bazı basit ama etkili önlemler var:
- Gıdaları kuru ve serin ortamda saklayın. Nemli ortamlarda küf oluşumu hızlanır.
- Ürünleri güvenilir markalardan ve güvenilir satıcılardan alın. Açıkta satılan ürünler daha fazla risk taşır.
- Ürün ambalajlarını ve son kullanma tarihlerini kontrol edin. Ambalajda nemlenme, küf kokusu gibi belirtiler varsa o ürünü tüketmeyin.
- Tahıl ve kuru baklagilleri hava almayan kaplarda saklayın.
- Evde nem oranını düşürmek için gerekirse nem alıcı cihazlar kullanın.